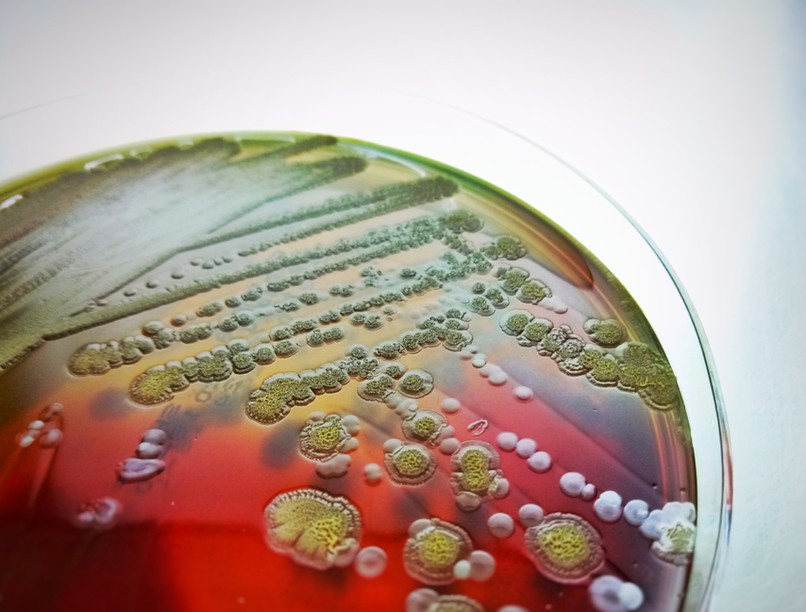
fulmináns szepszis oka tünete orvos válaszol

Tisztelt Doktorok! Édesanyám itthagyott minket mindenféle különösebb előzmény nélkül most hétfőn.
Múlt csütörtökön fájt a feje, este hányt, előtte volt egy orrfolyása, torokkaparása, az elmúlt napokban. Pénteken a hányás erőtlenné tette, ivott sokat, de feküdt, nem volt olyan aktív, mint szokott. Aznap be akartam vinni kórházba, hogy uh, vérkép alapján megnézhessék, de csak a körzeti orvosig mentünk, aki adott hányás csillapító injekciót, és Normix tablettát. Hasa betapintható volt, hólyagsérve fájt csak neki, és a dereka, de az már évek óta (kiszedték a méhét meg mindent odabent, hólyagsérvet hálózták 2019-ben).
Pénteken 1,5 liter vizet ivott, éjjel a fejfájás miatt 1* hányt talán. Szombaton testvérem elmondása szerint sokat aludt, de ivott, enni egy körtét evett csak. Nem mertem hozzá lemenni a 2 kisfiammal, mert féltem hogy covid vagy vmi más fertőző megbetegedés áll a háttérben.
Vasárnap hajnalban bevitte a mentő, éjjel hányt és ment a hasa, mentőben kapott infúziót, attól 2 perc után jobban lett, a kocsiban fel tudott ülni a székre. Apukám hívott reggel 7-kor, hogy kórházban van. Hívtam 9 körül a kórházat, kiderült, hogy a sokkolóban van, intubálták, kapott gyomorszondát és katétert. 273 volt reggel a pulzusa, kiütötték, majd altatták. A bélrendszerben lehet a kiinduló pont, szepszise van, de nem jönnek rá mi okozhatta, mert a máj, szív, agyi CT, minden röntgen jó lett neki.
Teljesen ledöbbentünk. Majd délután csörög a telefon, kérték, hogy menjünk be elbúcsúzni. Vasárnap bent volt az egész család, addigra már dialízist is kapott, lila volt a keze és lila foltos a lába... Hangunkra mintha reagált volna. Hétfőn engem újra bevitt hozzá a férjem, vittem neki az unokái kistakaróját, fényképét, illetve lejátszottam az általuk kért mama gyógyulj meg videóüzenetet. De ekkor mondta a kezelőorvos, hogy szerinte legfeljebb 24 órája van az életéből, mert a kapott kezelés ellenére, romlanak az értékei. Hétfőn délután a mi drága Mamónk elment, 66 évesen.
Kérdéseim, hogy
- 1 Ilyenkor lesz boncolás, hogy kiderüljön mitől lehetett a szepszis?
- 2 Magamat okolom, hogy mi lett volna, ha nem hallgatok a makacs anyukámra és fogom és beviszem kórházba? Élne még?
- 3 Nem volt külföldön, azt ette a héten mint apukám, nem vágta el az ujját.. Lehetséges, hogy volt vmi nagyobb gond a szervezetében, bélrendszer daganat amely ezt okozhatta, de nem mutatta ki egyik képalkotó diagnosztika sem?? 2018-ban melanómája volt, azt időben kivették, elvileg, de okozhatott áttétet mégis?
- 4 Vasárnap délelőtt állítólag magánál is volt egy kis ideig, reagált, majd mélyaltatásban volt, hallhatott minket? Beszéd közben a vérnyomása megemelkedett 90/60-ról 110/78-ra..vagy ez csak véletlen?
- 5 Legfontosahb, szenvedett vajon, fájt neki így elmenni?
- 6 2, 5 ill. 7 éves unokái vannak, nekik mesekönyveket rendeltem, ami az elmúlásról szól. Fogalmam sincs hogy fogják tudni feldolgozni, de félek attól hogy sérülnek, a mamájukat imádták.
Nagyon köszönöm, ha válaszolnak!
Az orvos válasza
Kedves Kérdező! Őszinte részvétem a váratlan és tragikus veszteségért, anyukája haláláért... nehéz szívvel olvasom a történetüket.
Nagyon tömör, tényszerű válaszok szintjén:
Lesz boncolás. Sajnos előfordul egy fulmináns szepszisben, hogy nem derül ki ebben a pár órában a góc. Lehetséges, hogy volt valami okkult ok a szervezetében, igen, de sajnos ennek az ellenkezője is lehet. Lehet összefüggés a melanómával, de semmiképpen sem közvetlen az összefüggés, ha van is. Tudom, ez kevés, de sajnos pont ennyit lehet elmondani. A fulmináns szepszis sajnos pont ilyen kegyetlen és felfoghatatlan.
Ami a fontosabb:
- 1 Talán hallhatta (de főleg: érezhette) magukat, erről sem lesz sosem biztos információjuk, de vannak ilyen klinikai tapasztalataink kritikus állapotú betegekkel. Egyébként ez inkább szép (még ha szomorú is), talán mindannyian jobban örülnénk, ha az utolsó napunkon még hallanánk vagy éreznénk azokat, akikért éltünk. Nagyon jó, hogy be tudtak menni hozzá.
- 2 Semmiképpen se okolja magát. A soraiból érződik, mennyire gondos és körültekintő, figyel az anyukájára, apukájára, gyerekeire, mindenkire.... nem tud egy szuverén felnőtt ember helyett felelősséget vállalni, és nem is kell. Ráadásul ezzel még csak azt sem sugallom, hogy az anyukája volt könnyelmű, sajnos PONT ennyire gyors és felfoghatatlan mindenkinek egy ilyen állapot alakulása, valószínűleg egyikük sem sejthette, mi következik. Nem tudjuk, élne -e még, de ennek a kérdésnek nincs is értelme és relevanciája, higgye el. Biztos, hogy nem a maga felelőssége volt.
- 3 Nem tudjuk, szenvedett -e, mit élt meg... de reméljük, azt megélte, hogy Önök ott jártak nála. Részben (bár nyilván nem csak ezért) azért is szedálták, hogy minél kevesebbet éljen meg, hogy amennyire tudja, bírja az állapotát.
- 4 Amit a gyerekei megsegítésére leírt, az szuper kiindulási alap, ebben talán Éva Salamon profibb, de az biztos, hogy tabusítani, tagadni, elhallgatni, hazudni nem szabad a gyerkeknek, beszélgetni viszont kell velük minderről, ennek csak előnye van, hátránya annak van, ha a beszélgetés nem történik meg, de érzékelik a gyászt, a tabut, a titkot, a feloldhatatlant. Jól csinálja, hogy erre külön ekkora figyelmet fordít.
Sok erőt kívánok maguknak!
<KÖVETKEZŐ CIKK>
Karsai Dániel: hogyan kell (jól) meghalni?

Kedves orvosok! Mélyen tisztelem Önöket. Dr. Karsai Dániel kapcsán kérdeznék.
Forrás: shuttertock.com
Kövesse az Egészségkalauz cikkeit a Google Hírek-ben, a Facebook-on, az Instagramon vagy a X-en,Tiktok-on is!